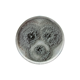

Tognana Talíř mělký Edge Iceland 27 cm porcelán 1 ks
472494
8056444436235 (kusový)
472494
Praha - Stodůlky
Změnit prodejnu
k 30.04.2026 05:00
0 balení
- HMOTNOST/OBJEM
- Hmotnost obsahu: 938g
- VÝROBCE
- Tognana Porcellane S.p.A., Via Capitello, 22 - 31030 Casier (Treviso) Italy
Popis a další doplňující informace:
- Země původu
- Turecko
- Výrobce / Distributor
- Tognana Porcellane S.p.A.
- Adresa výrobce / distributora
- Via Capitello, 22 - 31030 Casier (Treviso) Italy
- ROZMĚR / šířka x hloubka x výška /
- 27cm x 27cm x 2,5cm
- Počet balení v kartonu / paletě
- 6 / 360
Render here user shopping lists
Render here shopping cart details
Render here active store id in the mobile navigation

Vybraná prodejna Praha - Stodůlky
Vybraná prodejna
| Otevírací hodiny | |
| Po - So | 06:00 - 21:00 |
| Ne | 07:00 - 21:00 |
| Pro držitele zlatých a stříbrných karet | |
| Po - Pá | 05:00 - 21:00 |
Upozornění
Vážení zákazníci, momentálně evidujeme technický problém, který může u některých registrací způsobit nemožnost zaregistrovat se do Sortimentu online. Na opravě pracujeme. Omlouváme se za komplikace.